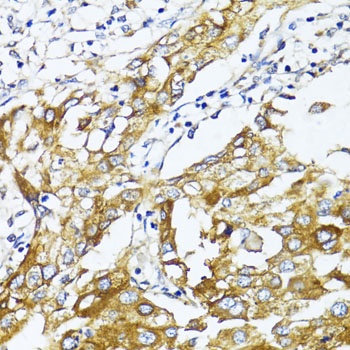
SLC2A4 Antibody

You have no items in your shopping cart.
- SLC2A4RG Rabbit Polyclonal Antibody [orb1351]Featured

IF, IHC-Fr, IHC-P, WB
Human, Mouse
Bovine, Sheep
Rabbit
Polyclonal
Unconjugated
50 μl, 100 μl, 200 μl - Glucose Transporter GLUT4/SLC2A4 Antibody [orb18036]
IHC, WB
Human, Mouse, Rat
Rabbit
Polyclonal
Unconjugated
100 μg - SLC2A4/GLUT4 Antibody [orb20638]
ELISA, IHC, WB
Human, Mouse
Bovine, Porcine, Rat
Goat
Polyclonal
Unconjugated
100 μg